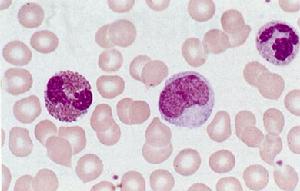
生白能

基本信息
白細胞形態
白細胞形態分類:促進白細胞增生藥
別名:人粒細胞巨噬細胞集落刺激因子、重組人粒細胞-巨噬細胞集落刺激因子、沙格莫丁、粒細胞-巨噬細胞集刺激因子、沙格司亭、莫拉司亭
外文名:RecombinatHumanGM-CSF、GM-CSF、rhGM-CSF、Levcomax、Sargramostim、Molgrastim
適應症
本品適用於癌症化療和在用骨髓抑制療法時所引起的白細胞減少症,亦適用於治療骨髓衰竭患者的白細胞低下,也可預防白細胞減少時可能潛在的感染併發症,還能使感染引起的中性粒細胞減少的恢復加快。
用量用法
本品為無菌乾凍粉劑,用稀積液溶解後,靜注或皮下注射。劑量視具體病情而定,應調節劑量使白細胞計數維持在所期望的水平,通常為低於10的9次方/L。在骨髓增生異常綜合徵,再生障礙性貧血伴白細胞減少,使用劑量為每公斤體重3μg,皮下注射,每日1次。癌症化療所引起的白細胞減少症為每公斤體重5~10μg,皮下注射,每日1次。在化療停止1日後方可使用,持續7-10日。骨髓移植,每日每公斤體重5~10μg,靜滴4~6h,每日1次。
藥物特點
性質
粒細胞一巨噬細胞集落刺激因子(簡稱:GM-CSF)是一種調節造血和白細胞功能所必須的蛋白質。重組人GM-CSF(rHuGM--CSF)是一種水溶性的,非糖基化的蛋白質,由127個胺基酸組成,分子量為14,477道爾頓。rHuGM--CSF系由一株帶有人類GM-CSF基因的質粒的大腸桿菌所產生,通過純化、製備而成。
藥代動力學
大鼠靜注125lrHuGM-CSF研究表明,核素活性在體內廣泛分布。給藥後很快被代謝和排泄。在猴、健康男性志願者和病人中均進行藥代動力學研究,其參數基本相似。志原者和病人皮下注射3、10或20(g/kg和注射3至30(g/kg,可觀察到血濃峰值和曲線下面積(AUC)隨劑量的增大而增高。皮下注射本品,在3-4小時血濃達到峰值。靜注本品的清除半衰期1-2小時,皮下注射則為2-3小時。
注意事項
 白細胞計算機圖
白細胞計算機圖大部分不良反應多屬輕度到中度,嚴重的或危及生命的反應罕見,並且一般是當劑量遠遠大於推薦劑量範圍時才發生。許多在臨床試驗期間所報導的不良反應,不一定能肯定地歸諸於生白能(Leucomax)的治療。因為它們很難與原發病的影響或其伴隨的治療相區別。接受骨髓移植病人,在用安慰劑對照實驗中發現,最常見的不良反應是發熱,可用撲熱息痛處理而緩解。
不良反應
1、常見的不良反應是發熱、皮疹。較少見的為低血壓、噁心、水腫、胸痛、骨痛和腹瀉。罕見的反應有變態反應、支氣管痙攣、心力衰竭、室上性心律失常、腦血管疾病、精神錯亂、驚厥、呼吸困難、肺水腫和暈厥等。偶見血清白蛋白水平低下。
2、禁用於對本品有過敏史的患者和自身免疫性血小板減少性紫癲的患者。3.孕婦不宜使用,哺乳婦女使用本品前應停止哺乳。
基本資料
規格
凍乾粉針劑:150μg(1.67×10^6μ)瓶、300μg(3.3×10^6μ)/瓶、700μg、50μg、100μg、250μg、400μg
保存期和儲存條件
生白能為無菌粉劑,分裝在工業小瓶內,用丁基成鹵代丁基橡膠塞密封,外加鋁製封口。於2-8℃,避光,要穩定保存36個月。如用無菌溶媒溶解後,置於冰櫃內(2-8℃)可保存1周。靜注稀釋液,置於冰櫃(2-8℃)。可保存24小時。必要時,生白能用溶媒溶解後,可以凍存28天。可以凍融二次。
生產企業
先靈葆雅
 先靈葆雅展位
先靈葆雅展位先靈葆雅公司(紐約證券交易所股票簡稱:SGP)是一家以科研為基礎的跨國製藥公司,在處方藥、健康消費品和動物保健等廣泛領域處於業界領先。公司通過內部研發及與戰略夥伴的合作,開發、製造並銷售先進的產品,以滿足諸多醫療需求。先靈葆雅公司及其全球33,500多名員工的願景是贏得得醫生、患者和客戶的信賴。先靈葆雅公司為120多個國家的患者和醫護人員提供產品,2006年淨收入達到106億美元。
公司在生物技術,基因組和基因療法領域中是公認的領先者。核心的產品結構包括過敏/治療呼吸系統疾病,抗感染/抗癌,皮膚及心血管疾病等系列產品。同時,先靈葆雅也擁有全球性的動物保健品、足部保健、非處方藥(OTC)、防曬保健方面著名的大眾品牌。創新的研發,高效的市場行銷和穩健的財務管理是使先靈葆雅實現年復一年增長,並保持優良的財務狀況的關鍵。先靈葆雅公司曾多次受到美國《財富》雜誌、《行業周刊》及多家權威機構肯定和好評。
發展歷史
1851年 ,恩斯特•先靈博士(Dr.Ernst Schering)在柏林購買了“綠色藥房”,創立了先靈公司。
1880年,先靈公司在美國成立分公司。
二十世紀四十年代是先靈葆雅發展的關鍵十年,它從一個歐洲公司兼有美國的營運方式變成為一個真正的美資企業
1952年 ,先靈公司通過轉為私企。葆雅公司是一家在美國田納西州的消費品公司。
 Fred Hassan
Fred Hassan1971年,先靈公司和葆雅公司正式合併,成立了先靈葆雅公司,組創了一個更具實力和多元化產品的製藥公司,先靈葆雅成為全球最重要的製藥公司之一。先靈葆雅公司集中在四個治療領域並持續疾病醫療研究的創新。先靈葆雅公司曾多次受到美國《財富》雜誌、《行業周刊》及多家權威機構肯定和好評。
1986年,先靈葆雅開始與中國合作。
2000年,先靈葆雅投資1.3億美元研發項目,比上年度增長12%。公司一貫支持研究領域的革新,並成為製藥行業中最先發現生物技術和基因療法的潛在優勢的公司之一。
2003年4月,Fred Hassan以執行總裁的身份加入先靈葆雅,經董事會選舉出任董事會主席。
中國概覽
1986年,先靈葆雅開始與中國合作。
 先靈葆雅在中國
先靈葆雅在中國目前已有11種進口及合資產品進入中國市場,至今已在全國三十幾個大中城市開展業務。
兒科常用藥物
| 兒科用藥是指套用於兒童患病所使用的藥物,尤其指專門在醫院兒科使用的藥品。一般來說,相同的品規藥品,只要適用於兒科,即可視為兒科藥品。 |

